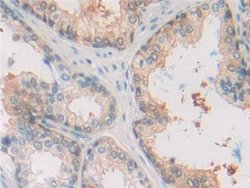
Invitrogen MIF Polyclonal Antibody 200 &mu;L | Buy Online | Invitrogen&trade; | Fisher Scientific

missing translation for 'onlineSavingsMsg'
Learn More
Learn More
Invitrogen™ MIF Polyclonal Antibody


Description
MIF Polyclonal Antibody for Western Blot, IHC (P)
MIF (macrophage migration inhibitory factor) was one of the first cytokine activities to be discovered and was initially described as a T cell-derived factor that inhibits the random migration of macrophages (Weiser 1989). Recently, MIF was rediscovered as a pituitary hormone that act as the counterregulatory hormone for glucocorticoid action within the immune system (Bernhagen 1993, Mitchell 1995). MIF was released from macrophages and T cells in response to physiological concentrations of glucocorticoids. The secreted MIF counter-regulates the immunosuppressive effects of steroids on immune cell activation and cytokine production (Bucala 1998). MIF plays a critical role in the host control of inflammation and immunity.

Specifications
Specifications
| Antigen | MIF |
| Applications | Immunohistochemistry (Paraffin), Western Blot |
| Classification | Polyclonal |
| Concentration | 0.5 mg/mL |
| Conjugate | Unconjugated |
| Formulation | PBS with 50% glycerol and 0.05% ProClin 300; pH 7.4 |
| Gene | Mif |
| Gene Accession No. | P14174, P34884 |
| Gene Alias | cytokine; delayed early response protein 6; DER6; GIF; GLIF; glutathione-binding 13 kDa protein; Glycosylation-inhibiting factor; HGNC:7097; L-dopachrome isomerase; L-dopachrome tautomerase; macrophage migration inhibitory factor; macrophage migration inhibitory factor (glycosylation-inhibiting factor); MGC107654; Mif; MMIF; phenylpyruvate tautomerase |
| Gene Symbols | Mif |
| Show More |
Product Title
By clicking Submit, you acknowledge that you may be contacted by Fisher Scientific in regards to the feedback you have provided in this form. We will not share your information for any other purposes. All contact information provided shall also be maintained in accordance with our Privacy Policy.
Spot an opportunity for improvement?